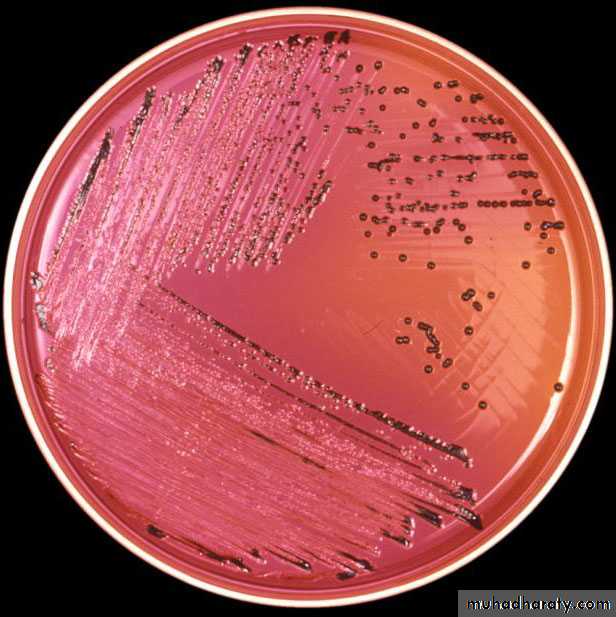

Enterobacteriaceae
Aim of these lecturesTo Know the medical importance of some bacteria related to this group
Reference:
Jawetz, Melnick & Adelberg s MEDICAL MICROBIOLOGY 25the EditionGenus Salmonella
ObjectivesDefine general structure, biochemical and diagnostic criteria of Salmonella
List the antigenic structure of salmonella
List diseases resulted from Salmonella infection
Describe the applied laboratory tests.
Analyze the results of serological test.
They are Gram negative rods, motile with peritrichous flagella except Gallinarum-pullorum
Ferment glucose and mannose acid only but not ferment lactose or sucrose.Salmonella are resistant to certain chemicals as Sodium deoxycholate or Sodium tetrathionate.
Survive freezing in water for long period
Aerobic and facultative anaerobes. Grow on simple media but some strains require enrichment media with one or more amino acids.
Salmonellae decarboxylate amino acids (lysine, ornithine and Arginine but not glutamic acid).
For I M V i C
/ | \ \
-ve +ve -ve +ve
Urease not produced
Produce H2S black color on kligler Iron agar or Triple Sugar Iron agar media.
Antigenic structure
1-Somatic O-Ag: side chain of repeating sugar projecting from the cell wall. They are hydrophilic, heat-stable Ags.
2-Flagellar H-Ag: represent determinant groups on the flagellar protein, they are heat-labile and Biphasic (phase I & phase II) detached flagella remains antigenic
non-motile salmonella
Others as
Fimbrial Ag (F-Ag) –just like flagellar detached by heating & cause confusing cross reaction
Capsular Ag (Vi-Ag) –acidic polysaccharide layer covering cell wall, also heat-labile.
M-Ag –lose extracellular polysaccharide
R-Ag –responsible for criteria (rough) mutation to S(smooth)
Pathogenesis
Most important pathogenic speciesS. typhi
S. Paratyphi A
S. Paratyphi B
S. Cholerasuis
Ingestion of food & water contaminated with human & animal wastes.
Typhoid fever transmitted only by humans.
Human sources either acutely infected persons
carriers
Animal sources through poultry and eggs.
In salmonella we need large infective dose due to effect of gastric acidity (at least 100.000).
Types of salmonella infections
1-EnterocolitisInvasion of epithelial & subepithelial tissues of S.I & L.I. organisms penetrate through the mucosal cells into lamina propria inflammation
Symptoms includes: nausea, headache, vomiting and profuse diarrhea and low grade fever but episode resolves within 2-3 days.
(stool culture usually positive for few weeks)
2-Bacteremia (5-10% of salmonella infection mainly caused by S.choleraesuis. Spreading to blood stream following oral infection causing focal lesions of many organs (lungs, bones, meninges … etc).
(Blood culture usually positive)
3-Enteric fever (Typhoid fever)
Mainly caused by S.typhiInfection start in S.I. multiply in peyers patches liver, gallbladder & spleen bacteremia.
Incubation period (10-14) days
Symptoms include: fever, malaise, headache, constipation and myalgia.
Signs include: bradycardia, hepatospleenomegaly and rose spots on a skin of abdomen & chest
WBC count may be low
Carrier state may develop in about 5% of patients due to invasion of gall bladder causing excretion of the bacteria in the feces.
Laboratory Diagnosis
Specimens include:
Blood for culture in bacteremia, and often positive from the 1st week in enteric fever
Bone marrow may be useful
Urine cultures may be positive after a second week.
Stool specimens positive in 2nd -3rd weeks in typhoid fever and usually positive in enterocolitis.
Duodenal drainage positive results in carrier state
Biopsy from rose spots
Serum (agglutinating Ab appear 2nd – 3rd weeks)
Bacteriologic methods:Culture on enrichment media (selenite F or tetrathionate broth) also on selective media (SS, Salmonella–Shigella, Bismuth sulfate black color of H2S
B-Serological test (Widal test)
Serum agglutinating Ab rise sharply during 2nd – 3rd weeks of typhoid fever.Serial dilutions of patient serum
Addition of fixed amount of Ags (O, H, Vi)
Agglutination will occur with dilution
Titer: is the reciprocal of the highest dilution of the patient serum which gives positive reaction.
Another test needed after 7-10 days
Results of Widal test
Anti – O: appear 2nd – 3rd week & stay for few weeks (>160)
Anti-H: remain high (>160) reflecting old infection or immunization.
Presence of anti-Vi occurs in carriers
Relapse may occur 2-3 weeks after recovery
Re-infection may occur but milder
Summary
- Salmonella are Gram’s negative rods producing H2S giving black colour on KIA and having somatic O antigen and flagellar H antigen.
- The most important pathogenic species are:
(S. typhi, S. Paratyphi A, S. Paratyphi B and S. Cholerasuis) which may cause enterocolitis, bacteremia or enteric fever (Typhoid fever).
- Lab diagnosis involve microscopical, cultural, biochemical and serological tests
Note: interpretation of Widal test results is the most important step in the diagnosis